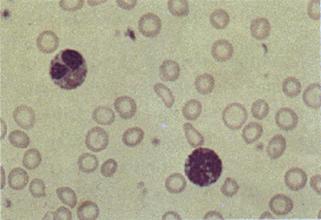

| CATEGORII DOCUMENTE |
| Alimentatie nutritie | Asistenta sociala | Cosmetica frumusete | Logopedie | Retete culinare | Sport |
Fiziopatologia seriei rosii
Hematopoeza


Eritropoeza


ANEMIILE
Definitie:
Barbati
Ø ↓ numarului de hematii < 4,5 milioane / mm3
Ø ↓ Hb < 14 g%
Femei
Ø ↓ numarului de hematii < 4 milioane / mm3
Ø ↓ Hb < 12 g%
Dpdv functional anemiile se caracterizeaza cel mai bine prin
concentratiei de Hb Þ capacitatii sangelui de a transporta O2


Clasificarea anemiilor
1. Clasificarea morfologica
A. hipocrome, microcitare
A. normocrome, normocitare
A. normocrome, MACROcitare
Clasificarea etiologica
A prin DEFICIT AL ERITROPOEZEI (¯ productiei)
A HEMOLITICE distructiei periferice)
Utilizarea logica a clasificarilor in investigarea anemiei
ANEMIE (Hb < 12 g%
Examenul sangelui periferic
Determinarea valorilor indicilor eritrocitari
CLASIFICAREA MORFOLOGICA
Teste de confirmare
CLASIFICAREA ETIOLOGICA
Clasificarea etiologica
Anemii prin DEFICIT AL ERITROPOEZEI
I. A prin alterarea metabolismului Fe
1. Anemia feripriva
2. Anemia sideroblastica
II. A. prin alterarea sintezei de ADN
1. Anemiile prin deficit de vitamina B12
2. Anemiile prin deficit de acid folic
III. A. prin deficit medular al eritropoezei
1. Primar: - anemia aplastica
- anemia mieloftizica
2. Secundar: - anemia din infectiile cronice
- anemia din IRC (uremia cronica)
- anemii din afectiunile hepatice
- anemii din endocrinopatii
Metabolismul fierului
Continutul total 3-4 g de Fe repartizate astfel:
-2/3 (2,5 g) Fe functional
- prezent in Hb, mioglobina, enzimele heminice
Fe din Hb (eliberat prin hemoliza eritrocitelor senescente) este integral reutilizat in eritropoieza
-1/3 (1 - 1,5 g) Fe de rezerva
depozitat in ficat, splina si maduva hematogena sub 2 forme:
feritina (usor mobilizabila
hemosiderina (lent mobilizabila
Pierderile zilnice de Fe
barbati: 1 mg/zi prin descuamarea celulelor mucoasei digestive, tegumentelor
femei: 1,5 mg/zi (+ hemoragiile menstruale)
Aportul de Fe
10-20 mg /zi sub 2 forme:
fier feros (Fe 2+)
fier feric (Fe 3+)


Absorbtia Fe:
- 5-10% din aportul zilnic
- se face la nivelul duodenului si jejunului superior :
fierul heminic (Fe 2+) se absoarbe ca atare
celelalte forme de Fe (Fe 3+) sunt convertite la fier feros sub actiune aciditatii sucului gastric
- ↑ absorbtiei Fe:
prezenta agentilor reducatori in alimente: ascorbatul (vitamina C), citratul
scaderea depozitelor (rezervelor) de Fe din organism
stimularea eritropoiezei (ex. in cazul ↓ nr. de eritrocite)
- ↓ absorbtiei Fe:
alimentatia bogata in cereale vegetale prin formarea de complexe insolubile ale Fe cu tanatii, fitatii, oxalatii si fosfatii
Transportul Fe in plasma:
legat de transferina (GP care fixeaza 3 atomi de Fe)
realizeaza sideremia concentratia Fe in sange) 60-190 μg%
saturatia cu Fe a transferinei
La nivel medular, transferina elibereaza Fe care va fi
utilizat in hemoglobinosinteza
depozitat in sideroblasti si macrofagele medulare
Circuitul Fe in organism


Cauzele anemiei feriprive
Apare in conditiile deficitului de Fe in organism dt. de
Ø cresterea necesarului utilizarii Fe:
sarcina si alaptare
perioadele de crestere rapida la copii
inflamatii cronice, neoplasme
tireotoxicoza
Ø scaderea absorbtiei:
malabsorbtia postgastrectomie
alimentatie bogata in fainoase si vegetale (cu formare de complexe insolubile)
Ø pierderi crescute
hemoragiile oculte digestive (gastrite, ulcere peptice, neoplasme digestive)
meno metroragii cu dismenoree cronica
paraziti intestinali si hemoroizi
Ø Fazele anemiei feriprive
FAZA I: Scaderea progresiva a depozitelor de fier
¯ feritinei serice < 20 ng/ml
- ¯ depozitelor de fier in macrofage la coloratia cu albastru de Prusia
- ¯ numarului de sideroblasti
- Hb, Ht, nr. H normale
- sideremie, CTLF (transferinemie), PEL normale
FAZA II: Deficit latent de fier, fara anemie
- depozite (rezerve) medulare de fier epuizate
- ¯ sideremiei
- ¯ saturatiei transferinei
- Hb, Ht, nr. H normale
- CTLF
FAZA III: Anemie normocroma normocitara
- ¯ sideremiei < 50 mg%
- ¯ saturatia transferinei < 15%
- ¯ Hb, ¯ nr. H
- indicii eritrocitari normali
FAZA IV: Anemie hipocroma microcitara
FAZA V: Anemie manifesta clinic
Anemia feripriva
Anemie hipocroma microcitara
cu depozitele de fier epuizate

Manifestarile clinice ale anemiei feriprive






Anemia sideroblastica
Definitie:
anemie hipocroma, microcitara cu
depozitele de Fe supraincarcate
Cauza: alterarea incorporarii Fe in hem
(in protoporfirina)
Caracteristici:
Maduva
↑ numarului sideroblastilor cu aparitia sideroblastilor inelari
depozite patologice (mitocondriale) sub forma de hemosiderina
hiperplazie medulara pe seria rosie cu eritropoeza inefectiva
Sg. periferic:
feritina serica
↑ sideremia > g%
↑ saturatia transferinei à
+ Depozite patologice de fier in organe (ficat, cord, pancreas, splina, tegumente
Circuitul Fe in organism


ANEMIA SIDEROBLASTICA
Clasificare:
Anemii sideroblastice primare
- rare, determinate genetic: X lincat autosomal recesiv
1. Forma PIRIDOXAL SENSIBILA
- raspunde la tratamentul cu vitamina B6
2. Forma PIRIDOXAL INSENSIBILA
- lipsa de raspuns la tratamentul cu vitamina B6
II. Anemii sideroblastice secundare
- inhibitia enzimelor din sinteza hemului in:
Inflamatii cronice
Stari canceroase sau preleucemice
Alcoolism cronic, intoxicatie cu plumb
Dupa medicamente: tuberculostatice, antibiotice, AINS
Metabolismul vitaminei B12 (cobalamina)
Sursa: alimente de origine animala
Necesar: 2,5 μg/zi
Absorbtie
in cursul digestiei gastrice se fixeaza pe o glicoproteina numita factor R complexul vitamina B12 - factor R este degradat in duoden unde vitamina B12 se fixeaza pe factorul intrinsec (FI = glicoproteina secretata de celulele parietale gastrice)
complexul B12 - FI se fixeaza pe receptori specifici din ileonul terminal unde vitamina B12 se absoarbe.
Transport in plasma transcobalaminele I si II
Depozitele: 2 mg in ficat suficiente pentru 3-6 ani in cazul sistarii aportului exogen
Rol: vitamina B12 are doua forme active:
Metilcobalamina
Adenozilcobalamina


Metabolismul acidului folic (pteroil-glutamic)
Aport: alimente de origine vegetala, sub forma de poliglutamat
Necesar μg /zi
Absorbtie: in jejunul proximal sub forma de monoglutamat
Transport in plasma : sub forma de N5-metil tetrahidrofolat (THF)
Depozitele:
10-20 mg in ficat sub forma de poliglutamat suficiente pentru 4 luni in cazul sistarii aportului
Rol:
Transfera gruparile cu 1 atom de carbon (metil, metilen, formil) pe compusi organici intervenind in sinteza de
Timidina
Metionina din homocisteina in prezenta vitaminei B12 ca si cofactor)
Purine
Anemia prin deficit de vitamina B12
Cauze:
Carenta alimentara
Tulburari de absorbtie:
lipsa F.I. (anemia pernicioasa, rezectii gastrice)
afectiuni ale ileonului terminal (boala Crohn, rezectii intestinale)
competitie pentru vitamina B12 sindromul de ansa oarba (cu staza si proliferare bacteriana), infestare teniazica, botriocefaloza
Cresterea ( ) necesarului in:
sarcina
cancere
tireotoxicoza
Anemia pernicioasa Addison - Biermer
Definitie: deficit congenital/dobandit de factor intrinsec (FI)
Patogeneza
scaderea absorbtiei vitaminei B12 datorita lipsei FI
alterarea mucoasei gastrice Þ atrofie prin mecanism autoimun (Ac anticelule parietale gastrice, Ac antifactor intrinsec
Manifestarile clinice sunt consecinta
Deficitului de metilcobalamina
Deficitul de adenozilcobalamina
Deficitul de metilcobalamina
Tulburari hematologice
a) Seria eritrocitara
la nivel medular hiperplazia seriei rosii, eritropoieza megaloblastica
in sangele periferic
anemie normocroma macrocitara (macrocite cu DEM 8-12 μ) si megalocitara (megalocite cu DEM > 12 anizo-poikilocitoza eritrocite cu fragmente nucleare: corpi Jolly si inele Cabot
b) Seria leucocitara
la nivel medular
mitoze atipice, metamielocite gigante
in sangele periferic
leucopenie ,aparitia de granulocite hipersegmentate
c) Seria trombocitara
la nivel medular
megacariocite gigante care se divid patologic
in sangele periferic
trombocitopenie
Eritropoeza megaloblastica




Deficitul de metilcobalamina
Tulburari digestive
atrofia mucoasei digestive:
- linguale (glosita Hunter)
- gastrice ( mecanismul autoimun)
- intestinale
achilie gastrica cu aclorhidrie histamino - rezistenta
incidenta crescuta a cancerului gastric
Testul Schilling
evidentiaza deficitul de absorbtie al vitaminei B12
Deficitul de adenozilcobalamina
Tulburari nervoase
Leziuni ale cordoanelor medulare dorsale si laterale
Leziuni ale nervilor periferici
demielinizare
degenerescenta axonala
Anemiile prin deficit de acid folic
Definitie: anemii normocrome macrocitare, dar cu absenta tulburarilor nervoase
Cauze:
carenta alimentara (alcoolismul cronic cu malnutritie)
malabsorbtie intestinala
interferarea metabolismului folatului
- carenta de vitamina C (necesara in reducerea acidului folic in forma sa activa de TH
- terapia anticanceroasa (Metotrexat, Ciclofosfamida - antagonisti ai acidului folic care inhiba dihidrofolat reductaza)
cresterea necesarului de acid folic (in sarcina, la copii cu crestere rapida)
Anemii prin deficit medular primar
Anemia APLASTICA
hipoplazie medulara severa, substituirea maduvei hematogene cu tesut adipos => pancitopenie periferica
Primare (½ cazuri sunt idiopatice) sau Secundare (intoxicatii cu benzen, compusi de arsen, expunere la radiatii ionizante, medicamente: fenitoin, cloramfenicol, antineoplazice de tip metotrexat )
Anemia MIELOFTIZICA
infiltrarea maduvei hematogene cu tesut tumoral sau granulomatos
Secundar in leucemii si limfoame, metastaze carcinomatoase, TBC avansat, dislipoidoze (boala Gaucher, Niemann-Pick)
Anemii prin deficit medular secundar
Anemia din INFECTIILE CRONICE
activarea macrofagelor SRE cu reducerea duratei de viata a eritrocitelor (hemoliza precoce), sechestrarea Fe in SRE
scaderea secretiei de eritropoetina
Anemia din IRC stadiul terminal de uremie cronica
scaderea secretiei de eritropoietina prin reducerea parenchimului renal, inhibitie medulara datorita toxinelor uremice
Anemia din AFECTIUNILE HEPATICE CRONICE (ciroza)
alcoolismul cronic determina - carenta de acid folic, deprimarea eritropoiezei
hemoliza prin aparitia acantocitelor, hemoragii gastrointestinale, hipersplenism cu scurtarea duratei de viata a eritrocitelor
Anemia din ENDOCRINOPATII
hipotiroidism, hipogonadism,
boala
↓ scaderea necesarului de O2 datorita ↓ metabolismului energetic in aceste stari hipometabolice
Clasificarea etiologica
Anemii HEMOLITICE
I. Prin defecte intracorpusculare:
1. Anemii hemolitice prin defecte ale membranei eritrocit.:
- acantocitoza
- microsferocitoza ereditara
2. Anemii hemolitice prin defecte enzimatice:
- in calea glicolizei anaerobe
- in shuntul pentozo-fosfatilor
3. Anemii hemolitice prin defecte ale Hb (Hb-patii/oze):
- calitative
- cantitative
II. Prin defecte extracorpusculare
1. Anemii hemolitice imune
2. Anemii hemolitice traumatice
Hemoliza extravasculara


Hemoliza intravasculara


! Caracteristica comuna tuturor a. hemolitice= RETICULOCITOZA
Anemii HEMOLITICE
Prin defecte ale membranei eritrocitare:
1. Acantocitoza
Cauze: abetalipoproteinemie, ciroza alcoolica/b. hepatice grave
Mecanism: exces de colesterol + continut normal de fosfolipide à rigiditatii eritrocitare Þ hemoliza extravasculara
2. Microsferocitoza ereditara
Cauze: afectiune ereditara autosomal dominanta
Mecanism:
- defect genetic de sinteza a proteinelor citoscheletului
- scaderea lipidelor membranare Þ ¯ suprafetei membranare Þ sferociteÞ hemoliza extravasculara
Tratament: splenectomia
Prin defecte enzimatice:
Ø Ale glicolizei anaerobe
Cauze: deficit de piruvatkinaza
Mecanism: ¯ sintezei de ATP Þ deficitul functional al pompei ionice Þ eritrocite rigide Þ hemoliza extravasculara
Ø Ale suntului pentozofosfatilor
Cauze deficit de G-6PD X lincat
Mecanism: ¯ glutationului redus Þ ¯ protectiei antioxidante Þ crize de hemoliza extravasculara declansate de:
infectii virale
medicamente oxidante
A. hemolitice prin defecte de sinteza ale Hb
Hemoglobinopatii calitative
A. Afectarea "buzunarului" heminic hidrofob
Methemoglobinemia ereditara
Hb cu afinitate crescuta
Hb cu afinitate scazuta
Hb instabile
B. Afectarea invelisului extern hidrofil:
Siclemia (anemia drepanocitara)
Hemoglobinopatii cantitative = TALASEMIILE
Hemoglobinopatii calitative
Mecanism: alterarea secventei de AA la nivelul lanturilor globinice
(prin substituirea unui AA cu altul
A. Afectarea "buzunarului" heminic hidrofob:
1. Methemoglobinemia ereditara transmitere autosomala dominanta, aparitia metHb cu afinitate ↑ pentru O2 si hipoxie tisulara
2. Hb cu afinitate crescuta pentru O2 - "Hb zgarcite", deviatia la stanga a curbei de disociere a oxiHb si hipoxie tisulara cu policitemie compensatorie
3. Hb cu afinitate scazuta pentru O2 (ex. Hb Kansas, Seattle)
- ¯ afinitatii Hb pentru O2, deviatia la dreapta a curbei de disociere a oxiHb, cianoza reversibila la administrarea de O2
4. Hb instabile
- oxidarea gruparilor -SH ale Hb Þ precipitarea Hb (corpii Heinz)
- rigidizarea eritrocitelor Þ hemoliza splenica
B. Afectarea invelisului extern hidrofil:
Hemoglobinoza S (siclemia, anemia drepanocitara)
- substituirea ac. glutamic cu valina in pozitia 6 a lantului = HbS
polimerizarea deoxiHb sub forma unor agregate dispuse liniar ca bastonase = siclizare, progresiv, pe masura desaturarii
- aparitia eritrocitelor rigide, in forma de de secera in sangele VENOS à obstructia vaselor microcirculatiei à infarcte tisulare si hemoliza splenica


Hemoglobinopatii cantitative
TALASEMIILE
Hemoglobina


Hemoglobina


Hemoglobinopatii CANTITATIVE
Mecanism:
deficit partial sau total de sinteza a lanturilor α sau globinice
A. Alfa - talasemia
Mecanism: deletia genelor ce codifica sinteza lanturilor α (cr. 16)
Patologic: mutatia genetica consta in deletia genelor ce codifica sinteza lan urilor alfa => Hb anormale
B. Beta - talasemia
Mecanism: deletia genelor ce codifica sinteza lanturilor (cr. 11)
Normal: exista 1 gena ce codifica sinteza lanturilor pe fiecare cr. 11
Patologic: mutatia genetica poate fi:
Beta - talasemia minor :
- defect heterozigot Þ anemie usoara microcitara, HbA2
Beta - talasemia major (Anemia Cooley) :
- defect homozigot
Þ anemie severa hipocroma si microcitara
Þ supraincarcarea depozitelor de Fe depozite patologice in miocard si ficat
Þ Splenomegalie
Þ Hiperplazie medulara pe seria rosie cu reticulocitoza
Þ ingrosarea oaselor craniene si fracturi pe os patologic
Þ HbF
Anemii IMUNOHEMOLITICE
Mecanismul hemolizei prezenta anticorpilor (Ac) antieritrocitari
Anemii imunohemolitice cu Ac la cald
anticorpii reactioneaza la temperatura corpului (37 de grade)
IgG orienta i impotriva Ag Rh se fixeaza pe membrana eritrocitelor = sensibilizare Þ captare de catre macrofagele splenice Þ hemoliza extravasculara prin eritrofagocitoza
idiopatice sau secundare (limfoame, leucemii, Hodgkin, LES, α - metildopa)
Testul COOMBS = intens pozitiv - test de evidentiere a anticorpilor antieritrocitari
Ø Testul Coombs direct evidentiaza Ac antieritrocitari fixati pe eritrocite
Ø Testul Coombs indirect evidentiaza Ac antieritrocitari liberi in plasma
. Anemii imunohemolitice cu Ac la rece
anticorpii reactioneaza la rece (4 grade C)
aglutinine din clasa IgM orientate impotriva Ag I eritrocitar sau Ac din clasa Ig G
C3 se fixeaza pe suprafata eritrocitelor Þ hemoliza intravasculara prin activarea complementului
b. limfoproliferative (LLC) mononucleoza infectioasa afectiuni virale sifilis
Testul Coombs direct este pozitiv
Anemii hemolitice induse medicamentos
a) mecanismul haptenei
induse de medicamente (penicilina) care se poate fixa pe proteine din membrana eritrocitelor (este un Ag incomplet - haptena) à sinteza de Ac (IgG) impotriva complexului eritrocit-medicament (reactie de HS tip II)
|
Politica de confidentialitate | Termeni si conditii de utilizare |
Vizualizari: 6697
Importanta: ![]()
Termeni si conditii de utilizare | Contact
© SCRIGROUP 2025 . All rights reserved